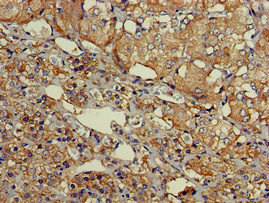

SLU7 Antibody
-
中文名稱:SLU7兔多克隆抗體
-
貨號(hào):CSB-PA021783LA01HU
-
規(guī)格:¥440
-
圖片:
-
Western Blot
Positive WB detected in: K562 whole cell lysate, Mouse brain tissue
All lanes: SLU7 antibody at 3μg/ml
Secondary
Goat polyclonal to rabbit IgG at 1/50000 dilution
Predicted band size: 69 kDa
Observed band size: 69 kDa -
Immunohistochemistry of paraffin-embedded human liver cancer using CSB-PA021783LA01HU at dilution of 1:100
-
Immunohistochemistry of paraffin-embedded human adrenal gland tissue using CSB-PA021783LA01HU at dilution of 1:100
-
Immunofluorescent analysis of A549 cells using CSB-PA021783LA01HU at dilution of 1:100 and Alexa Fluor 488-congugated AffiniPure Goat Anti-Rabbit IgG(H+L)
-
-
其他:
產(chǎn)品詳情
-
產(chǎn)品名稱:Rabbit anti-Homo sapiens (Human) SLU7 Polyclonal antibody
-
Uniprot No.:
-
基因名:
-
別名:9G8 antibody; hSlu7 antibody; MGC9280 antibody; Pre mRNA splicing factor SLU7 antibody; Pre-mRNA-splicing factor slu7 antibody; SLU 7 antibody; slu7 antibody; SLU7 splicing factor homolog (S. cerevisiae) antibody; SLU7 splicing factor homolog antibody; SLU7_HUMAN antibody; splicing factor antibody; Step II splicing factor SLU7 antibody; Zinc knuckle motif containing antibody
-
宿主:Rabbit
-
反應(yīng)種屬:Human, Mouse
-
免疫原:Recombinant Human Pre-mRNA-splicing factor SLU7 protein (138-310AA)
-
免疫原種屬:Homo sapiens (Human)
-
標(biāo)記方式:Non-conjugated
本頁(yè)面中的產(chǎn)品,SLU7 Antibody (CSB-PA021783LA01HU),的標(biāo)記方式是Non-conjugated。對(duì)于SLU7 Antibody,我們還提供其他標(biāo)記。見(jiàn)下表:
-
克隆類型:Polyclonal
-
抗體亞型:IgG
-
純化方式:>95%, Protein G purified
-
濃度:It differs from different batches. Please contact us to confirm it.
-
保存緩沖液:Preservative: 0.03% Proclin 300
Constituents: 50% Glycerol, 0.01M PBS, pH 7.4 -
產(chǎn)品提供形式:Liquid
-
應(yīng)用范圍:ELISA, WB, IHC, IF
-
推薦稀釋比:
Application Recommended Dilution WB 1:500-1:5000 IHC 1:20-1:200 IF 1:50-1:200 -
Protocols:
-
儲(chǔ)存條件:Upon receipt, store at -20°C or -80°C. Avoid repeated freeze.
-
貨期:Basically, we can dispatch the products out in 1-3 working days after receiving your orders. Delivery time maybe differs from different purchasing way or location, please kindly consult your local distributors for specific delivery time.
-
用途:For Research Use Only. Not for use in diagnostic or therapeutic procedures.
相關(guān)產(chǎn)品
靶點(diǎn)詳情
-
功能:Required for pre-mRNA splicing as component of the spliceosome. Participates in the second catalytic step of pre-mRNA splicing, when the free hydroxyl group of exon I attacks the 3'-splice site to generate spliced mRNA and the excised lariat intron. Required for holding exon 1 properly in the spliceosome and for correct AG identification when more than one possible AG exists in 3'-splicing site region. May be involved in the activation of proximal AG. Probably also involved in alternative splicing regulation.
-
基因功能參考文獻(xiàn):
- these findings indicate that SLU7 is co-opted by hepatocellular carcinoma (HCC) cells and other tumor cell types to maintain survival, and identify this splicing regulator as a new determinant for the expression of the oncogenic miR-17-92 cluster. This novel mechanism may be exploited for the development of antitumoral strategies in cancers displaying such SLU7-miR-17-92 crosstalk PMID: 26804174
- SLU7 knockdown in liver cells resulted in profound changes in pre-mRNA splicing and gene expression, leading to impaired glucose and lipid metabolism, refractoriness to key metabolic hormones, and reversion to a fetal-like gene expression pattern. PMID: 24865429
- These observations together point to an altered recruitment and dependence on SLU7, suggesting its role in facilitating transitions that promote catalysis, and highlight the diversity in spliceosome assembly. PMID: 23754748
- RBM22 and hSlu7 differ significantly in their subcellular distributions under stress conditions, and RBM22 enhances the cytoplasmic translocation of hSlu7 under stress. PMID: 21122810
- The zinc-knuckle motif of hSlu7 determines the cellular localization of the protein through a nucleocytoplasmic-sensitive shuttling balance. PMID: 15181151
- hSlu7 has a broad effect on alternative splicing PMID: 15728250
- Regulation of transcription of the RNA splicing factor hSlu7 by Elk-1 and Sp1 affects alternative splicing PMID: 17804646
顯示更多
收起更多
-
亞細(xì)胞定位:Nucleus. Nucleus speckle. Cytoplasm.
-
蛋白家族:SLU7 family
-
數(shù)據(jù)庫(kù)鏈接:
Most popular with customers
-
-
YWHAB Recombinant Monoclonal Antibody
Applications: ELISA, WB, IHC, IF, FC
Species Reactivity: Human, Mouse, Rat
-
-
-
-
-
-